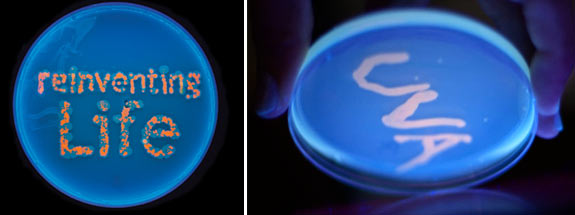

Reinventing Life
The strange and wondrous science of biological technology
Students at the University are creating new organisms by splicing DNA. How does synthetic biology work? What are its dangers and benefits? And how might it change the world?
Last summer in a Gilmer Hall lab, Dan Tarjan and a team of fellow undergraduates created a new living organism.
Using buckets of ice, vials of bacteria and “BioBricks”—strings of DNA manufactured in California—they altered the genetic code of E. coli so that the bacteria would absorb arsenic.
“What we made are tiny machines; they’re devices,” says Tarjan (Col class of ’10), the team leader. “Synthetic biology is figuring out what different pieces of DNA do so that they can be reassembled in new ways to create new functions.”
The team brought its “arsenic scrubbers” to iGEM, an international competition at MIT, where it vied for awards against 110 other teams that had created new living things. A team from Italy tailored bacteria to efficiently turn waste from dairy products into ethanol that might be useful as fuel. A team from Canada concocted bacteria that would transform sugars people eat into indigestible cellulose while in the digestive tract, which might make people thinner.
The competition is evidence that bioengineering, once the purview of only the most sophisticated labs, is now within the reach of college students. Not all the projects that teams bring to the contest are successful, but a growing body of nonproprietary information and faster, more powerful computers have made creating new organisms more accessible than ever.

Tinkering with living things at such a fundamental level—their DNA, the blueprints of life—carries significant responsibilities for those who do it and consequences that will likely affect many facets of our lives. Even scientists who are enthusiastic about its potential acknowledge that it is difficult to foresee how it will change our world. “DNA is extremely complex; the cell is extremely complex; living organisms are extremely complex; and ecosystems are extremely complex,” says Jason Papin, a professor of biomedical engineering at UVA. “So yes, there is a lot of uncertainty when it comes to making changes to any of these things.”
History suggests that those uncertainties will not slow the pace of advance. “When in history have we not used a technology that we developed, even when it had terrifying potential risks?” asks Michael Shirts, professor of chemical engineering at UVA.
The motivation for students like Tarjan to build living machines is not only to win awards but also to help solve real-world problems. The UVA team won gold at the competition at MIT because they successfully demonstrated that their creation absorbed arsenic and that it had possible practical applications in places like Bangladesh, where groundwater is often poisoned with arsenic.
“I don’t want to overestimate what we can currently do. Synthetic biology is a new field, the tools are still fairly rudimentary, the process is tedious and we often resort to a trial-and-error approach,” says Tarjan. “But it holds tremendous promise to solve big problems. That’s what I want to do.”
Cell Reproduction 101
The structure of DNA, twisting like a spiral staircase, is a familiar image. But what is it, really? “As with everything in the cell,” says Papin, “it comes down to proteins.” DNA is built out of four kinds of molecules, called adenine (A), guanine (G), cytosine (C) and thymine (T), that when grouped into threes become amino acids. In turn, when amino acids are combined, they form proteins.
“Every cell in nature is a thing of wonder. Even the simplest are far beyond the limits of human ingenuity. To build the most basic yeast cell, for example, you would have to miniaturize about the same number of components as are found in a Boeing 777 jetliner and fit them into a sphere just five microns across; then somehow you would have to persuade that sphere to reproduce.”
—From A Brief History of Nearly Everything by Bill Bryson
“Proteins are the workers of the cell; they do everything from eating sugar to copying information to transforming molecules,” says Papin. In the case of DNA, sequences of proteins encode the blueprints for a cell or organism. The most essential property of DNA is that it can make copies of itself. This is critical when cells divide because each new cell needs to have a copy of the DNA that was in the old cell.
Every living thing has DNA, but there are different ways in which each individual organism ends up with its specific set of instructions for life. New copies of DNA tend to be similar to the DNA from which it is derived—just as children tend to resemble their parents—but DNA also has methods for changing itself.
The first way is cloning. Bacteria make replicas of themselves with exactly the same DNA in each new cell. In nature, bacteria sometimes swap DNA with each other—something scientists call promiscuity. Synthetic biologists often use bacteria because their natural promiscuity makes it easier to insert new pieces of DNA into them.
The second way is sexual reproduction. Apart from bacteria, 99.9 percent of living things use sexual reproduction, which combines the DNA from two organisms to create a completely new organism with its own unique DNA. Think of it: Every person, with the exception of identical twins, has DNA unlike any other person.
The third way is mutation. Sometimes DNA just changes. It might occur when DNA copies itself and inserts a molecule of adenine where a molecule of cytosine should be. Other times, an external factor such as radiation damages DNA. The results of change can be either good or bad; mutation can do anything from allow bacteria to live in a difficult environment to cause cancer cells to grow inside a body.
Since its discovery in the mid-20th century, the purposeful manipulation of DNA has become a fourth method of change. “Whereas in the past there were natural mutations and adaptations, we might now imagine directed evolution,” says Papin.
Tarjan’s team performed just this sort of manipulation when they inserted pieces of DNA into already existing bacterial pathways. “Ultimately, however, we’ll be able to build biological systems from scratch, linking parts together like pieces of Lego.”
The ethics of altering living things
Just because new biological technology is making the creation of new organisms possible doesn’t necessarily mean it should be done. Ethicists warn that all the possible outcomes and side effects of new life must be considered. What will be the effects on the environment? Will there be consequences for human society? What about the affected organisms themselves?
The unintended consequences of importing new animals into non-native environments are plentiful. For example, a population of rabbits originally brought to Australia for food grew exponentially, destroyed habitats and caused the extinction of many native animals.
“There is fear that because living organisms are self-replicating, any mistakes that are made will grow exponentially and of their own accord,” says Douglas Taylor, an evolutionary biologist and chair of UVA’s biology department. In 1975, when the potential of recombinant DNA—which refers to DNA sequences that aren’t found in nature but rather are artificially coded by combining DNA from two or more natural sources—was first coming to light, the Asilomar Conference was held to address the safety of and ethical concerns about the technology. The conference resulted in voluntary safety guidelines, and recombinant DNA has dominated biological research since.
“With bacteria, the suffering of a genetically modified organism isn’t really an issue, but what about animals? How much are we already willing to let a cow suffer for our benefit? How much would we be willing to let a genetically engineered creature suffer?”
—Margaret Foster Riley, law professor
Genetically modified life isn’t just in labs—it’s all around us. Genetically modified plants are being used in agriculture all over the world—except in countries where they are banned. Much of the corn, soybeans and cotton that Americans consume has been genetically modified.
It might be argued that we’ve been genetically modifying plants and animals for far longer than we’ve even known about the existence of DNA. “We humans have always used nature to fulfill our own needs,” says Deborah Johnson, who teaches applied ethics at the School of Engineering and Applied Science. “We’ve always been dependent for our very survival on other living things. Not only that, but we’ve intentionally and unintentionally been altering living things so that they are more useful to us. That’s what breeding animals for domestication is all about.”
Through selective breeding over thousands of years humans altered the DNA of the crops that we eat and even the animals that we keep as pets. “Certainly, God didn’t make Corgies,” says Margaret Foster Riley, a UVA professor who studies law related to biotechnology, food and animals. “We made Corgies, just like we selected for the yeast that made the best beer and the bacteria that made the tastiest cheese.”
“Like most technology, synthetic biology has a possible dark side and a potential to do tremendous good,” says Riley. Johnson warns that, like other technologies in the modern era, biological technology will likely cause faster change than our society has experienced before. “When change happens over centuries—such as with the slow domestication of a plant species—there are more opportunities to adapt to it, to find solutions for any problems that the change creates,” she says.
Is synthetic biology too unpredictable to use safely? “As long as we are being deliberate and careful about the experiments,” says Papin, “why would we exclude a tool that has so much potential?”
But isn’t it wrong to meddle with nature?
The creation of genetically modified organisms has been criticized by environmentalists who fear the destruction of ecosystems, and by people concerned about who might own certain organisms or technologies. Some people simply find the idea creepy. Other objections stem from religious beliefs.
“Many of us come from a Judeo-Christian background that postulates that making life is the domain of God. In that tradition, those who crossed into what was God’s exclusive purview were often punished,” explains Riley. From a secular perspective, many people feel that nature is a delicate balance that is in danger of being disrupted. “People deify nature,” says Riley. “They feel that nature is wiser than people ever could be.”
Johnson argues that we might need to reconsider our basic assumptions about nature. “There has been a perception that things that are ‘natural’ are good and things that are ‘artificial’ are bad. Cotton equals good. Polyester equals bad.” But this is not necessarily true. Things that exist in nature are not always good for us, and artificial things are often good. There are plants that can poison us. Many medicines are not just good for us but make the difference between life and death.
“There may be a false dichotomy between ‘natural’ versus ‘artificial,’” explains Johnson. “Also, we need to remember that humans have been interacting with nature for so long that there really is no clear line between the natural and artificial. We are part of nature and nature is significantly shaped by us.” Johnson suggests that we might start to think of human effects on other living organisms as a natural process, like the moon causes the tides or the change of seasons causes leaves to fall. Could humans just be another cause of evolutionary change, not unlike natural selection? Could we direct our own evolution?
“Historically, society doesn’t deal fairly with difference, and genetically modified people would be different. What if human genetic modifications were very expensive? Do we want to live in a world where the rich benefit from bodies—and maybe even minds—that work better than those of the poor? For me, it isn’t the science that is scary, but rather the social consequences of the science.”
—Inchan Kwon, professor of chemical engineering
Maybe nature isn’t as well balanced as we imagined in the first place. “In our culture, there is a perception that nature is perfect, that everything in nature is optimized and perfectly balanced, that every niche is filled,” says Taylor. “That just isn’t true. Invasive species prove this time and again. A plant or animal that thrives in a new environment finds a new niche and proves that there was previously unused potential in an ecosystem. This is also true of DNA. If you assume that genes put into the genome will not escape into the wild because any unnatural alteration must be deleterious, you are giving too much credit to the evolutionary process as having explored all the options and arrived at the best.”
Are there improvements that might be made to our genes? Already, scientists have designed crops with higher yields, fruit that travels better and even bacteria that can produce human insulin to treat diabetes.
What’s next?
Inchan Kwon studies how viruses can be used to deliver medicines—or even new and better genes—to cells that need them. Geneticist Francis Collins (Col class of ’70) and his colleagues have identified genes that cause diseases such as cystic fibrosis, neurofibromatosis and Huntington’s disease. What if we could use devices created with synthetic biology to fix our DNA? Gene therapy is still in its infancy, but it is one of the ways in which new biological technology might be used in humans.
“There is a moral line between using biological technology on a cow and on a human,” says Kwon. So far there have been far fewer experiments with human subjects than animals. This includes gene therapy experiments that might eventually benefit humans. Many species have been cloned successfully, but human cloning is banned. Yet science fiction writers and scientists alike are envisioning the potentials of changing human DNA.
“History suggests it’s going to happen,” says Shirts. “For a technology to be suppressed, everyone has to agree to ban it. For a technology to be used, only one person needs to use it. Which is more likely? Who doesn’t want to be stronger, thinner, healthier? We need to start figuring out right now how to lay down the rules so that it’s used in the most beneficial way possible.”
Manipulating the DNA of humans has all the dangers of doing so in other creatures—only with clear costs in human suffering. Johnson says that only hubris could allow us to believe that we might foresee, let alone understand, all of its consequences. Shirts goes further and says that when scientists first start working with human DNA, “we’re going to botch it, with both immediate and long-term consequences. In biological systems as complex as humans there will be mistakes and unintended side effects when DNA is modified. There will be mutations that have extreme consequences for the individuals in which they appear; most mutations are harmful, certainly not like X-Men.”
Depending on who’s talking about biological technology, the future is described as either a utopia—in which our needs are fulfilled by nanomachines and we are healthier than ever before—or a catastrophe in which unrecognizable plants and animals run amok. Riley says it’s more likely that we will follow a middle path between the two scenarios. Both scientists and ethicists seem to agree that decisions about how technology is used should be made openly and with the benefit of an informed public. “There is always discomfort with new technology,” says Riley. “We need to make decisions together as a society; we must consider the risk of using it and the opportunity costs of not using it.”

